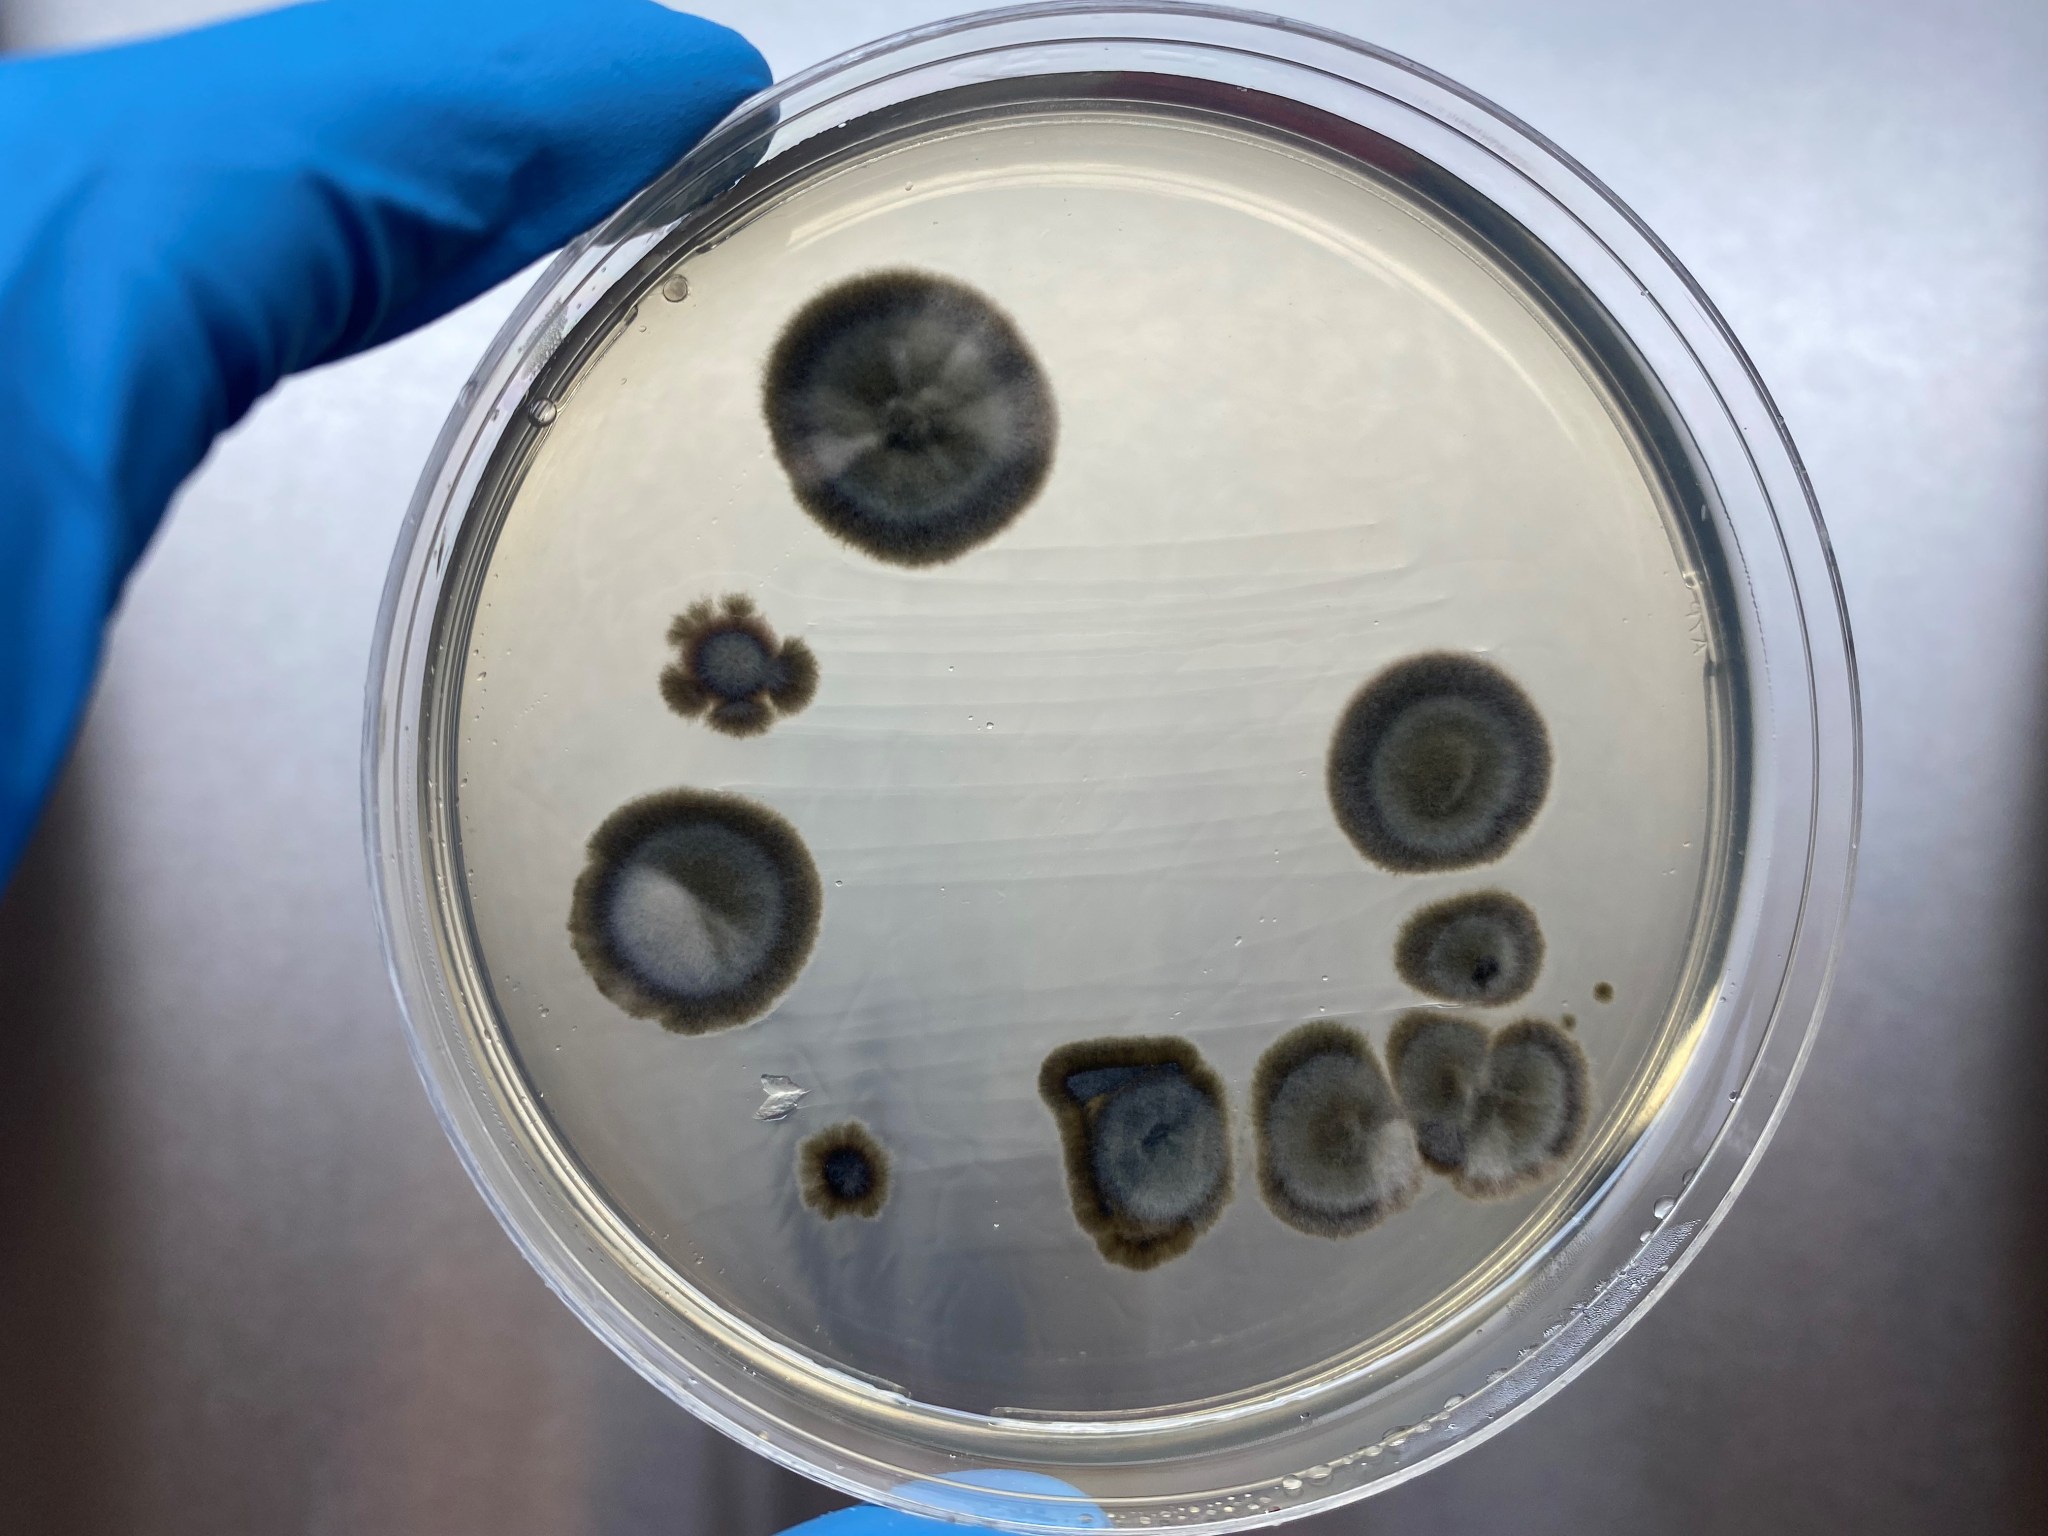

By Celine Smith
As NASA continues its exploration of the solar system, including future crewed missions to Mars, experts in the agency’s Office of Planetary Protection are developing advanced tactics to prevent NASA expeditions from introducing biological contaminants to other worlds.
At NASA’s Marshall Space Flight Center in Huntsville, Alabama, the Planetary Protection team is contributing to this work – pursuing new detection, cleaning, and decontamination methods that will protect alien biospheres, safeguard future planetary science missions, and prevent potentially hazardous microbes from being returned to Earth. The Planetary Protection team is a part of the Space Environmental Effects (SEE) team in Marshall’s Materials and Processes Laboratory.
Planetary Protection microbiologist Chelsi Cassilly said much of Planetary Protection focuses on “bioburden” which is typically considered the number of bacterial endospores (commonly referred to as “spores”) found on and in materials. Such materials can range from paints and coatings on robotic landers to solid propellants in solid rocket motors. NASA currently requires robotic missions to Mars meet strict bioburden limits and is assessing how to apply similar policies to future, crewed missions to the Red Planet.
“It’s impossible to eliminate microbes completely,” Cassily said. “But it’s our job to minimize bioburden, keeping the probability of contamination sufficiently low to protect the extraterrestrial environments we explore.”
Currently, Marshall’s Planetary Protection research supports NASA’s Mars Ascent Vehicle, a key component of the planned Mars Sample Return campaign, and risk-reduction efforts for the Human Landing System program.
Critically, Planetary Protection prevents the introduction of microbes from Earth onto planetary bodies where they might proliferate and subsequently interfere with scientific study of past or current life there. If Earth’s microbes were to contaminate samples collected on Mars or Europa, the scientific findings would be an inaccurate depiction of these environments, potentially precluding the ability to determine if life ever existed there. Preserving the scientific integrity of these missions is of the utmost importance to Cassilly and her team.
Contamination mitigation tactics used in the past also may not work with modern hardware and materials. For the Viking missions to Mars, NASA employed a total spacecraft “heat microbial reduction” (HMR) process, a prolonged exposure to high temperatures to kill off or minimize microbes. As spacecrafts advance, NASA is more discerning, using HMR for components and/or subassemblies instead of the entire spacecraft.
According to Cassilly, HMR may not always be an ideal solution because, extended time at high temperatures required to kill microbes can degrade the integrity of certain materials, potentially impacting mission success. While this is not a problem for all materials, there is still a need to expand NASA’s repertoire of acceptable microbial reduction techniques to include ones that may be more efficient and sustainable.
To contribute to NASA’s Planetary Protection efforts, Cassilly undertook a project – funded by a Jacobs Innovation Grant – to build a microbial library that could better inform and guide mitigation research. That meant visiting cleanrooms at Marshall to collect prevalent microbes, extracting DNA, amplifying specific genes, and submitting them for commercial sequencing. They identified 95% of the microbes within their library which is continually growing as more microbes are collected and identified.
The Planetary Protection team is interested in taking this work a step further by exposing their microbial library to space-like stressors—including ultraviolet light, ionizing radiation, temperature extremes, desiccation, and vacuum—to determine survivability.
Understanding the response of these microbes to space environmental conditions, like those experienced during deep space transit, helps inform our understanding of contamination risks associated with proposed planetary missions.

Chelsi Cassilly
Planetary Protection microbiologist
“The research we’re doing probes at the possibility of using space itself to our advantage,” Cassilly said.
Cassilly and Marshall materials engineers also supported a study at Auburn University in Auburn, Alabama, to determine whether certain manufacturing processes effectively reduce bioburden. Funded by a NASA Research Opportunity in Space and Earth Sciences (ROSES) grant, the project assessed the antimicrobial activity of various additives and components used in solid rocket motor production. The team is currently revising a manuscript which should appear publicly in the coming months.
Cassilly also supported research by Marshall’s Solid Propulsion and Pyrotechnic Devices Branch to assess estimates of microbial contamination associated with a variety of commonly used nonmetallic spacecraft materials. The results showed that nearly all the materials analyzed carry a lower microbial load than previously estimated – possibly decreasing the risk associated with sending these materials to sensitive locations.
Such findings benefit researchers across NASA who are also pursuing novel bioburden reduction tactics, Cassilly said, improving agencywide standards for identifying, measuring, and studying advanced planetary protection techniques.
“Collaboration unifies our efforts and makes it so much more possible to uncover new solutions than if we were all working individually,” she said.
NASA’s Office of Planetary Protection is part of the agency’s Office of Safety and Mission Assurance at NASA Headquarters in Washington. The Office of Planetary Protection oversees bioburden reduction research and development of advanced strategies for contamination mitigation at Marshall Space Flight Center; NASA’s Jet Propulsion Laboratory in Pasadena, California; NASA’s Goddard Space Flight Center in Greenbelt, Maryland; and NASA’s Johnson Space Center in Houston.
For more information about NASA’s Marshall Space Flight Center, visit: